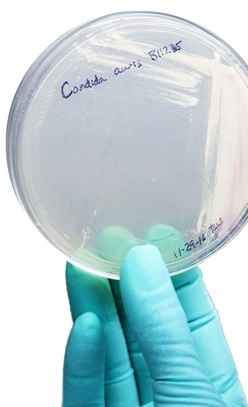
A strain of Candida auris cultured in a petri dish at CDC. image Credit: CDC

Latest reports have confirmed that over 200 patients in England have been infected with a drug-resistant fungus called Candida auris that was first detected in Japan. High alerts have been put in place to look out for further infections and prevent spread.
As of now according to the Public Health England there have been no deaths due to this infection in the UK. However this fungus is capable of causing serious bloodstream and wound infections the officials have said. In many persons there may be no symptoms at all.
A strain of Candida auris cultured in a petri dish at CDC. image Credit: CDC
The first case of Candida auris infection was detected in 2013 in UK. The rates of infection have steadily increased since then. The fungus further is difficult to curb because it is developing resistance to most of the anti-fungal drugs that are being used. According to the officials, till the end of last month, the infection has spread to 20 separate NHS trusts and independent hospitals in the UK. A further 35 other hospitals have also been known to have patients transferred to them who had been detected with Candida auris.
Of these hospitals afflicted, three large hospitals have faced large outbreaks of the infection that became difficult to contain. The largest of the hospital outbreaks was at the Royal Brompton Hospital in London. This involved 50 patients and started in April 2015. This was despite all the infection control and containment measures that were adopted. The outbreaks now are over though said Public Health England but the threat for infections remain.
According to Dr Colin Brown, from Public Health England's national infection service, the cases that came to light were all detected due to routine screening rather than in patients who developed symptoms. Of all the infected persons, 27 developed bloodstream infections he said. He assured that the patients in healthcare settings are at low risk because of the intensive surveillance system that is in place to prevent and detect infections. He also assured that there have been no deaths till now despite the outbreaks and PHE has upgraded its infection-control guidance for hospitals and nursing homes and equipped them with the capacity to detect, control and contain any further infections. Patient information leaflets have also been distributed, he added, so that patients can know when they have the infection from the symptoms.
Candida auris
Candid species of fungi are common and usually live on the skin and inside the human body normally. Candida albicans, is one of the well known yeasts of fungi that affects humans leading to thrush. Thrush can occur in the mucosal surfaces notably within the mouth or oral thrush etc.
Candida auris was first detected in 2009 in the ear of a patient from Japan. Since then this species of Candida has affected and caused outbreaks in several hospitals worldwide - notably in United States, India, Pakistan, Venezuela, Colombia, Israel, Oman, South Africa and Spain and the UK.
This fungi usually spreads via contact from person to person via clothing or equipment. It may take only a few hours for an infection to spread within a hospital.
Candida auris in general may not cause symptoms but may cause serious blood infections in some individuals. For diagnosis the fungi can be detected in the body fluids from the swabs used to take samples. Spread can be stopped by maintaining good hygiene. Protective clothing and gloves help stop spread.
As of now this fungi is resistant to most antifungal agents such as azoles, echinocandins, and polyenes and thus infection is difficult to treat. A biosafety unit at Porton Down, the UK’s chemical weapons lab, is testing for fungicides that can be used to prevent spread of the infection within the hospitals.
References
- https://www.cdc.gov/fungal/diseases/candidiasis/candida-auris-qanda.html
- https://www.rbht.nhs.uk/
- https://www.cdc.gov/